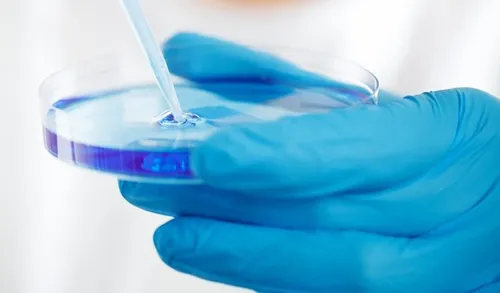
Imagem ilustrativa da imagem Infertilidade atinge 351 mil pessoas no ES

Infertilidade atinge 351 mil pessoas no ES
Por causa disso, mais casais têm buscado ajuda de especialistas para a tão sonhada gravidez
Estimativa da Organização Mundial da Saúde (OMS) aponta que 17,5% da população adulta sofre de infertilidade. Considerando a última Projeção da População, feita pelo Instituto Brasileiro de Geografia e Estatística (IBGE), no Estado há 351 mil pessoas inférteis, entre 18 e 50 anos.
Por causa disso, mais casais têm buscado ajuda de especialistas para a tão sonhada gravidez. “Os tratamentos de reprodução assistida, incluindo a fertilização in vitro, têm sido cada vez mais procurados, pela dificuldade que os casais vêm enfrentando devido aos inúmeros fatores que podem estar associados à infertilidade”, destaca a ginecologista Isabela Rangel.
Ronney Vianna Guimarães, ginecologista com enfoque em Reprodução Humana Assistida, explicou que cerca de 35% das causas de infertilidade são relacionadas ao homem, 35% às mulheres, 20% são mistas e 10% são idiopáticas, ou seja, são de causas desconhecidas.
“Dentre as causas femininas, o principal fator é a idade da mulher, e isso é também representado pelos problemas de ovulação”, destaca.
Além da idade, problemas como endometriose e síndrome dos ovários policísticos também são sinais de alerta para a infertilidade. “Também existe relação entre o estilo de vida e a fertilidade. Estudos apontam, por exemplo, que o tabagismo pode diminuir a qualidade dos óvulos”, alerta Ronney.
MATÉRIAS RELACIONADAS:
















Comentários